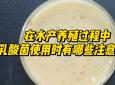
乳酸菌阴胶囊的功效(乳酸菌阴胶囊，维护女性私处健康)

为什么说女人滴风油精能上天(安全吗)
为什么说女人滴风油精能上天
风油精含有一定的酒精含量,以及一些刺激性物质,可能会出现所有刺激性症状,但一般情况下不会留下后遗症,如果没有不舒服的症状,如水肿、瘙痒、皮肤溃烂等,那么就没有问题,暂时观察,今后应注意局部卫生,穿纯棉宽松内衣,早晚用温水清洗。
根据不少的医生判断,觉得阴道滴风油精数量过多,会有特别辣的感觉,甚至会使阴道发生水肿等情况,而且风油精具有很强的渗透作用,可以轻松的进入人体,风油精进入阴道会引起炎症的刺激性疼痛,容易引起阴道出血以及阴道炎。所以,在此建议大家不要尝试这种行为,因为一旦形成刺激性的问题,近期的生活状况都会受到影响,如果已经有了这种行为,建议大量喝水,注意观察问题是不是特别严重,最好考虑到医院解决一下这种现象。

女生滴风油精是个什么梗?
7月23日晚,韩熙雅在手印直播时,因被蚊子叮咬,所以拿出风油精涂抹。此时有观众提出:“你往下面滴风油精,我就给你刷岛(价值人民币1500元 的礼物)!”其他观众也纷纷附和鼓动。面对几万名观众的起哄,韩熙雅先是拿风油精涂抹了胸部,并表示“毫无感觉”,然后又撑开短裤往下体滴了几滴。还不到 五秒钟,风油精带来的刺痛感就让她大哭,随后狂奔至厕所清洗。可没想到此时用清水清洗已不起作用,韩熙雅不断哭求观众提供止痛方法。由于疼痛实在无法忍 受,韩熙雅选择拨打了120,并关掉直播表示要去就医。
为什么说风油精能上天
有的人听说使用风油精过后可以提升性功能,其实并不建议大家这样做,因为风油精的刺激性比较大,生殖器官的皮肤比较薄,也比较敏感,反而容易对身体造成不好的影响。如果想要提高性功能能,建议使用专门的产品,比如印度神油这种成人用品来提升战斗力,印度神油是一个有助于延长房事时间的安全产品,使用后能帮助降低敏感度,延时达到40分钟以上,它是一个具有针对性的产品,适合时间短、龟头易敏感,早泄的人群使用。为确保效果,大家一定要到正规的地方购买,同时严格按照要求来使用。
为什么女人都喜欢用风油精,而且经常带着,这是为什么?
出门在外难免会被虫咬什么,蚊子咬的话可以搽,还有就是像有时天气太热会头晕,风油精搽搽可以缓解。还有搽在鼻子下面可以提神。我是女生,我觉得随身带着风油精不麻烦,还可以预防些小状况。带着好以防万一又不是很麻烦。
如果您觉得本文对您有帮助,请关注我们,好东西网将持续分享更多生活知识。
1.《为什么说女人滴风油精能上天(安全吗)》援引自互联网,旨在传递、分享更多网络信息知识,仅代表原作者观点,与本网站无关,侵删请联系站长。
2.《为什么说女人滴风油精能上天(安全吗)》仅供读者参考,本网站未对该内容进行证实,对其原创性、真实性、功效性、完整性、及时性不作任何保证。
3.文章转载时请保留本站内容来源地址:https://haodonxi.com/ask/4591.html
-
M指的是什么(字母圈抖m指的是什么)
M指的是什么1 抖m和抖s在生活中不常见,如果不是熟悉动漫圈或者电竞圈的小伙伴很难知道抖m和抖s是什么意思。2 抖m和抖s这两个词主要在动漫
-
为什么一用精油就特别快(为什么一用精油就特别快射精)
为什么一用精油就特别快为什么一用精油就特别快射精?1 如果是擦在阴茎龟头部位,想射精的话,一般多见于龟头,阴茎受到刺激导致,另外也可
-
什么精油可以提高女性功能(改善性功能用什么精油)
什么精油可以提高女性功能卵巢功能比较弱的情况下您可以考虑玫瑰精油比较好,子宫补品、对妇科诸症有良好疗效;调节月经、增加精子、改善男
-
什么东西可以充当人体润滑油(什么可以作为人体润滑油)
什么东西可以充当人体润滑油橄榄油、香油、色拉油、蜂蜜等物质都可以充当人体润滑油,在物质匮乏的年代,这些都是经常被用来互相替代用来润
-
神油对性功能有伤害吗(神油有什么效果)
神油对性功能有伤害吗有一定的伤害和副作用。所谓印度神油,其实就是延时喷剂,大部分都是含有局部麻醉药成分的喷剂,由于不是按药品生产的
-
男人能用玫瑰精油提高性功能(保养男性功能用什么精油好)
男人能用玫瑰精油提高性功能1 男性使用玫瑰精油并不能够达到提高性能力的效果,不过,它能够帮助缓解精神压力。2 在帮助改善睡眠效果上效果
-
清凉油壮阳涂什么地方(清凉油涂抹哪里可以补肾)
清凉油壮阳涂什么地方1 清凉感当男人把清凉油涂抹在自己阴茎上之后,短短几秒钟他就能体会到什么叫做真正“刺激”,即便是当时没有任何性欲
-
为什么说女人滴风油精能上天(风油精上天真的吗)
为什么说女人滴风油精能上天风油精含有一定的酒精含量,以及一些刺激性物质,可能会出现所有刺激性症状,但一般情况下不会留下后遗症,如果
-
长期不性生活的危害(长期不性生活有什么坏处)
长期不性生活的危害听起来像是给性生活找了个理由,但是却是真实的。长期不性生活有什么坏处?我们认为可能如下:1、你压力更大一个美好的
-
男性长时间没有性生活的表现(男的长期没有性生活会出现什么症状)
许多男人性欲很强,似乎在思考。有时是因为他们是一名球员,但有时是因为他们只是单纯的机器。男性长时间没有性生活的表现和症状包括:1、
-
老鼠肉的功效与作用(老鼠肉的营养价值及保健功效)
老鼠肉的功效与作用 老鼠肉作为一种传统的食材,一直以来都备受争议。但是,它却有着一些令人惊讶的功效与作用。以下是老鼠肉的功效与作用
-
雌激素乳膏的功效(雌激素乳膏:美丽胸部的秘密)
雌激素乳膏的功效 雌激素乳膏是一种外用药膏,主要成分是雌激素。它可以帮助女性缓解更年期症状,预防骨质疏松症,改善皮肤质量等。下面我
-
牛大力酒的功效与作用(牛大力酒:强效提神,增强体力)
牛大力酒的功效与作用 1 强身健体 牛大力酒是一种传统的中药酒,由多种草药和动物性原料制成。其中含有丰富的蛋白质、氨基酸、维生素等
-
乳酸菌阴胶囊的功效(乳酸菌阴胶囊,维护女性私处健康)
乳酸菌阴胶囊的功效 乳酸菌阴胶囊是一种以乳酸菌为主要成分的保健品,主要用于女性私处的保健。乳酸菌阴胶囊的功效主要体现在以下几个方面
-
葵花双唑泰栓的功效(葵花双唑泰栓-治疗阴道炎、宫颈炎的好选择) ...
葵花双唑泰栓的功效 葵花双唑泰栓是一种常用的阴道药物,主要用于治疗阴道炎、宫颈炎、阴道病变等妇科疾病。它的主要成分是葵花双唑,是一